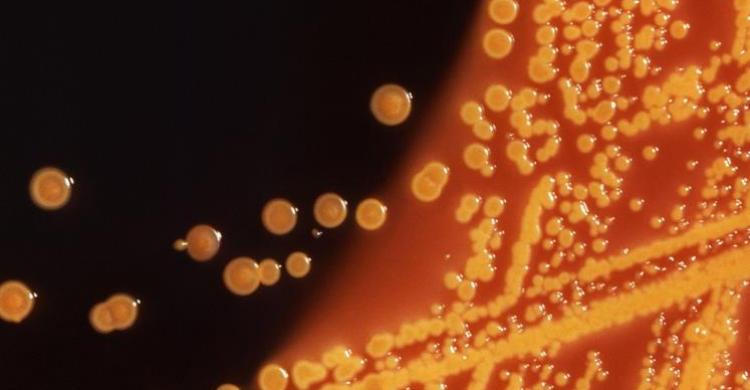

شمس نيوز / وكالات
أكد فريق بحثي إسكتلندي إمكانية تعليم الحاسوب كيفية اكتشاف أنواع البكتيريا التي يمكن أن تسبب التسمم الغذائي للإنسان.
وتركز الدراسة التي أجراها فريق بحثي من معهد روزلين التابع لجامعة أدنبرة على الأنواع الضارة من بكتيريا "إي كولاي"، وهو ما يمكن أن يساعد العاملين في مجال الصحة العامة.
وتعتمد الدراسة على استخدام برنامج حاسوب لتحليل البيانات الجينية الخاصة بعينات بكتيرية من البشر والحيوان.
ويستطيع البرنامج التعرف على البصمة الوراثية المرتبطة بأنواع بكتيريا إي كولاي، وتحديد الأنواع الضارة التي يمكن أن تتسبب في انتقال العدوى إلى الإنسان، حسبما أوضح الموقع الإلكتروني "ساينس ديلي" المعني بالأبحاث والابتكارات العلمية.
وتعيش معظم أنواع بكتيريا إي كولاي في أمعاء الإنسان والحيوان دون التسبب في حدوث أي مشكلات صحية، ولكن فصيلة إي كولاي أو 157 (Escherichia coli O157) مرتبطة بأمراض أكثر خطورة على الصحة.
وتعيش فصيلة إي كولاي أو 157 في أمعاء الأبقار التي تعتبر مخزنا رئيسيا لهذه البكتيريا السامة، وتخرج هذه البكتيريا في فضلات الماشية دون أن تسبب لها أي مشكلات صحية، وهو ما يجعل من الصعب التعرف على الحيوانات التي تحمل هذه الفصيلة البكتيرية الضارة.
ودرب فريق الباحثين برنامج حاسوب على تحليل البصمة الوراثية للبكتيريا التي تؤخذ من قطعان الماشية أو المرضى من البشر في المملكة المتحدة والولايات المتحدة، وأصبح بمقدور البرنامج تحديد ما إذا كانت هذه البكتيريا مصدرها حيواني أو بشري.
ومن خلال هذا البرنامج، توصل الباحثون إلى أن أقل من 10% من فصيلة إي كولاي أو 157 يمكن أن تسبب أمراضا للبشر، وبالتالي من الممكن اتخاذ إجراءات صحية لوقف انتشار المرض عن طريق حملات تطعيم تستهدف قطعان الماشية التي تحمل في أمعائها هذه الفصيلة المميتة من البكتيريا، وهو ما يقلل من احتمالات انتقال العدوى إلى البشر، حسبما يقول الفريق البحثي.
ويقول البروفسور ديفد جالي من معهد روزالين بجامعة أدنبرة إن هذه الدراسة تسلط الضوء على إمكانية استخدام برامج الحاسوب في التعرف على الأنواع الضارة من البكتيريا والحيلولة دون تفشي الأوبئة والأمراض المعدية.
ويؤكد الباحثون إنه من الممكن استخدام التقنية نفسها لاختبار عينات من أنواع أخرى من البكتيريا المأخوذة من الحيوانات مثل السالمونيلا أو البكتيريا المسببة لداء العطائف الذي يعرف باسم "كامبيلوباكتر" وغيرها، وبالتالي التعرف على الفصائل التي يمكن أن تشكل خطورة على صحة الإنسان.